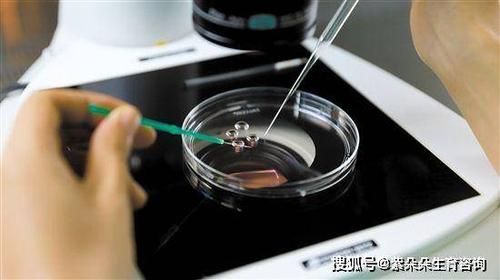
供卵试管被骗【供卵试管被骗：背后的真相】

供卵试管被骗是一个备受关注的话题,随着人们对生育技术的需求增加,一些不法机构和个人也趁机进行欺诈行为。本文将深入探讨供卵试管被骗背后的真相,帮助大家更好地了解这一问题。
1. 供卵试管背后的利益链
供卵试管被骗的背后往往隐藏着复杂的利益链。一些不法机构或个人通过向供卵者承诺高额报酬来吸引她们参与供卵,然而实际操作中往往存在着违法行为和不当利益输送。一些不法中介机构也会通过虚假宣传和欺骗手段来获取利益。
2. 供卵者的权益保障
供卵者作为生育技术的参与者,其权益应当得到充分保障。然而在现实中,供卵者往往处于信息不对称和弱势地位,容易成为欺诈行为的受害者。建立健全的法律法规和监管机制,加强对供卵试管行业的监管,保护供卵者的合法权益至关重要。
3. 识别供卵试管骗局的方法
为了避免成为供卵试管骗局的受害者,供卵者需要提高警惕,学会识别骗局。要选择正规的生育技术机构,避免与非法中介合作。要了解自己的权益和义务,不轻易相信高额报酬的承诺。要通过法律途径保护自己的权益,一旦发现受骗,要及时报警和寻求法律援助。
4. 建立健全的供卵试管行业
除了供卵者个人的防范意识,建立健全的供卵试管行业也是预防骗局的重要手段。政府部门应当加强对生育技术机构和中介机构的监管,严格规范行业秩序,打击违法行为。加强对供卵者的宣传教育,提高其识别骗局的能力,有助于减少供卵试管被骗事件的发生。
相关问答:
问:供卵试管被骗对供卵者有哪些危害?
答:供卵试管被骗不仅可能导致供卵者的经济损失,还可能对其身体健康和心理健康造成影响。
问:政府应当如何加强对供卵试管行业的监管?
答:政府可以通过建立健全的法律法规和监管机制,加强对生育技术机构和中介机构的监管,严格打击违法行为,保护供卵者的合法权益。











